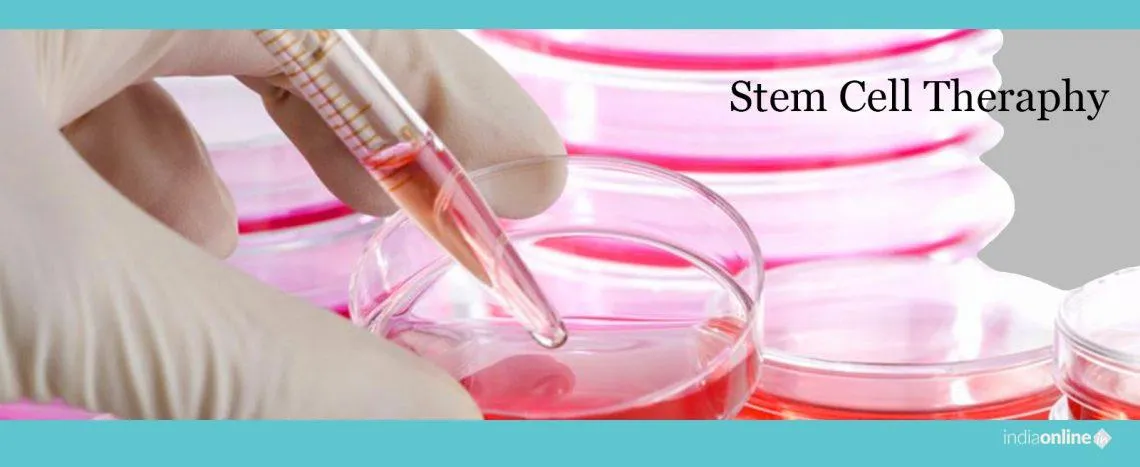
Scala Clinics

Frequently Asked Questions (FAQs)
Question 1: What is the address of Scala Clinics?
Answer: The complete postal address of Scala Clinics is: H No 1-2-25/1 First Floor, Near Mallikarjhuna Bharamaba Theatre, Jntu Kukat Pally - 500085, Hyderabad, Telangana
Question 2: What Treatments & Services are offered by Scala Clinics?
Answer: Scala Clinics primarily offers Skin & Hair Treatment Clinics Treatments & Services, including Body Hair Transplantation, Facial Hair Tranplantation, STD & Leprosy Treatment, Vitiligo Treatment, Psoriasis infection Treatment, Bacteria Infection Treatment, Fungal Infection Treatment, Unwanted Hair Removal, Pits Treatment, Botox Treatment, Skin Tightening Treatment, Anti Aging Treatment, Skin Polishing Treatment, Skin Rejuvenation, Under Eye Dark Circles Treatment, High Frequency Therapy, Freckles Treatment, Melasma Treatment, Skin Lightening Treatment, Dark Spot Treatment, Tattoo Removal Treatment, Anti Dandruff Treatment, Low Level Laser Therapy, PRP Therapy, Stem Cell Therapy for Hair Loss, Hair Transplantation, Mole and Warts Removal Treatment, Acne Treatment, Scar Treatment, Pimple Treatment, PRP (Platelet-Rich Plasma) Therapy, Hair Transplantation, Mole and Wart Removal, Vitiligo Treatment, Skin Biopsy and Pathology, Eczema and Psoriasis Treatment, Skin Allergy Testing, Tattoo Removal, Laser Hair Removal, Pigmentation Treatment, Laser Therapy, Scar Revision, Skin Rejuvenation, Botox, Anti-Aging Treatments, Acne Treatment, Skin Tightening, Body and Facial Sculpting, Skin Lightening Treatments, Skin Treatments, Laser Hair Removal Treatment, Laser Treatment For Tattoo Removal, Laser Mole Removal Treatment, Laser Treatment For Skin Whitening, Laser Treatment For Piles, Laser Treatment For Acne, Laser Wart Removal Treatment, Laser Treatment For Scar, Laser Treatment For Vitiligo, Laser Treatment For Pigmentation, Laser Treatment For Varicose Veins, Laser Corn Removal Treatment, Laser Treatment For Birth Mark Removal, Skin Care Treatments, Treatments For Spot Reduction, Under Eye Treatment, Stem Cell Hair Regrowth Treatment, Treatments For Acne, Skin Hydrating Treatment, Treatments For Wrinkle Remover, Treatments For Forehead Wrinkle, Treatment For Dull Skin, Premature Graying Hair Treatment, Treatment Hair Laser Therapies, Cosmetic Laser Procedures, Body Contouring, Botox Injections, Hair Analysis and Diagnosis, Dandruff and Scalp Conditions, Hair Loss Prevention, Laser Hair Therapy, Mesotherapy for Hair, Hair Spa and Treatments, Hair Regrowth Treatments.
Question 3: What are the working hours of Scala Clinics?
Answer: Scala Clinics operates from 8:00 AM to 9:00 PM throughout the week, Monday to Sunday.
Question 4: How can I contact Scala Clinics?
Answer: You can directly contact Scala Clinics through calling them or through WhatsApp using the "Call" or "Chat" button below. The best way to contact them is by filling the enquiry form and sharing your requirements with them and Scala Clinics will call you back with best deals.
Question 5: In which year was Scala Clinics established?
Answer: Scala Clinics was established in 2010.
Question 6: Are there any current deals or special offers available at Scala Clinics?
Answer: Scala Clinics currently offers: Special Offer - Special Offer Free Check Up Doctor Consultation/Skin/Hair/Analysis test Dirt Couselling Give a Missed Call - 7416422444Upto 30% off - Limited Time Offer Skin & Hair Treatments now get at - 499 only
Question 7: Can customers leave reviews for this business?
Answer: Yes, customers can leave reviews for Scala Clinics to share their feedback and experiences, and they can also upload photos along with their reviews. The current rating given to Scala Clinics by 5 users is 4.8 out of 5. You can give your review for Scala Clinics by clicking here.
Skin & Hair Treatment Clinics in Popular Cities
- Skin & Hair Treatment Clinics in Agra
- Skin & Hair Treatment Clinics in Ahmedabad
- Skin & Hair Treatment Clinics in Amritsar
- Skin & Hair Treatment Clinics in Aurangabad
- Skin & Hair Treatment Clinics in Bareilly
- Skin & Hair Treatment Clinics in Bengaluru
- Skin & Hair Treatment Clinics in Bhopal
- Skin & Hair Treatment Clinics in Bhubaneswar
- Skin & Hair Treatment Clinics in Chandigarh
- Skin & Hair Treatment Clinics in Chennai
- Skin & Hair Treatment Clinics in Coimbatore
- Skin & Hair Treatment Clinics in Delhi
- Skin & Hair Treatment Clinics in Dhanbad
- Skin & Hair Treatment Clinics in Dharwad
- Skin & Hair Treatment Clinics in Gurugram
- Skin & Hair Treatment Clinics in Guwahati
- Skin & Hair Treatment Clinics in Hyderabad
- Skin & Hair Treatment Clinics in Indore
- Skin & Hair Treatment Clinics in Jaipur
- Skin & Hair Treatment Clinics in Jodhpur
- Skin & Hair Treatment Clinics in Kanpur
- Skin & Hair Treatment Clinics in Kochi
- Skin & Hair Treatment Clinics in Kolkata
- Skin & Hair Treatment Clinics in Kota
- Skin & Hair Treatment Clinics in Kozhikode
- Skin & Hair Treatment Clinics in Lucknow
- Skin & Hair Treatment Clinics in Ludhiana
- Skin & Hair Treatment Clinics in Madurai
- Skin & Hair Treatment Clinics in Mira-Bhayandar
- Skin & Hair Treatment Clinics in Mumbai
- Skin & Hair Treatment Clinics in Mysuru
- Skin & Hair Treatment Clinics in Nagpur
- Skin & Hair Treatment Clinics in Navi Mumbai
- Skin & Hair Treatment Clinics in Noida
- Skin & Hair Treatment Clinics in Patna
- Skin & Hair Treatment Clinics in Pimpri Chinchwad
- Skin & Hair Treatment Clinics in Prayagraj
- Skin & Hair Treatment Clinics in Pune
- Skin & Hair Treatment Clinics in Raipur
- Skin & Hair Treatment Clinics in Rajkot
- Skin & Hair Treatment Clinics in Ranchi
- Skin & Hair Treatment Clinics in Siliguri
- Skin & Hair Treatment Clinics in Surat
- Skin & Hair Treatment Clinics in Thane
- Skin & Hair Treatment Clinics in Thiruvananthapuram
- Skin & Hair Treatment Clinics in Vadodara
- Skin & Hair Treatment Clinics in Vijayawada
- Skin & Hair Treatment Clinics in Visakhapatnam
Popular Categories in Hyderabad
- Travel Agents & Tour Operators in Hyderabad
- Massage & Spa Parlours in Hyderabad
- Movers & Packers in Hyderabad
- Pest Control Service Providers in Hyderabad
- Home Nurse & Domestic Help Agencies in Hyderabad
- Investment Advisors & Consultants in Hyderabad
- Lawyers in Hyderabad
- Digital Marketing & Website Designing Companies in Hyderabad
- CCTV & Security System Dealers in Hyderabad
- Hotels & Resorts in Hyderabad
- Home Appliances & Electronics Repair Service Providers in Hyderabad
- Caterers in Hyderabad
- Computer Training Institutes in Hyderabad
- Hospitals & Clinics in Hyderabad
- Legal Documents & License Agents in Hyderabad